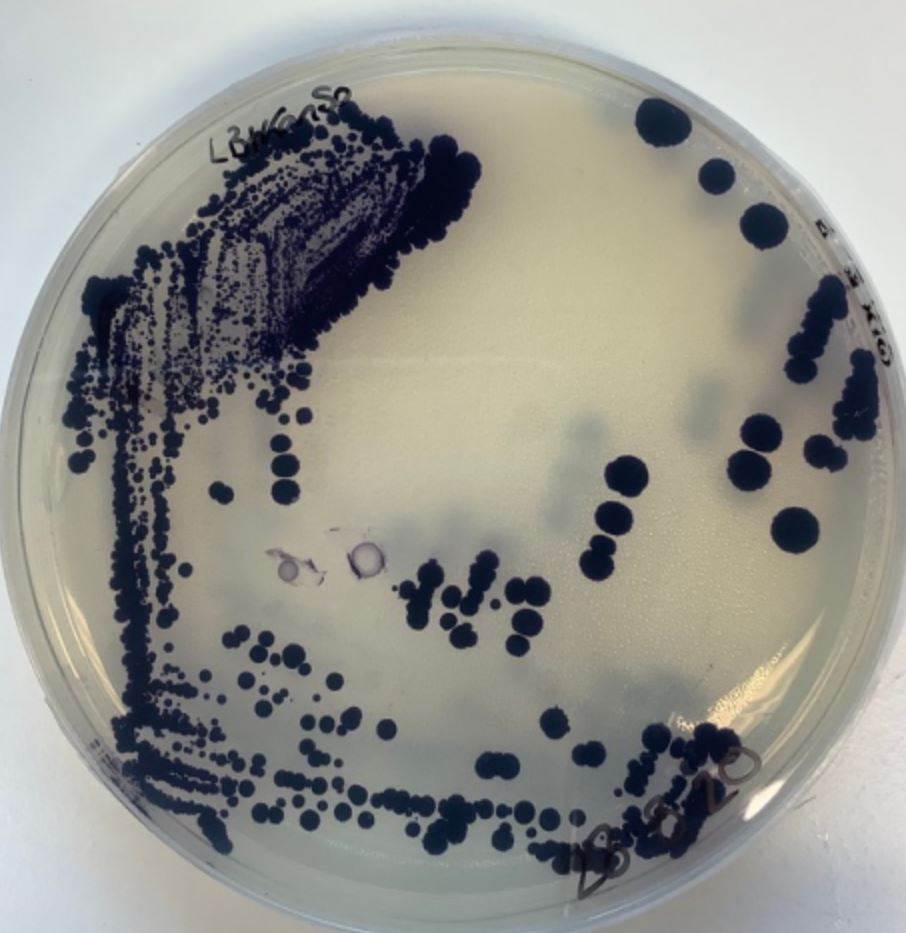
Bio dye technology receives £18 million boost

Bio dye technology receives £18 million boost
01/06/2022
The money will also enable the company to treble its team and expand in Europe and Asia, “implementing its technology into the supply chains of several brands”.
Its main operations are based in Cambridge, and it is setting up an office in Portugal.
Its process finds colours created by an organism in nature - whether an animal, plant, insect or microbe - and pinpoints the genes that lead to the production of the pigment, which is then translated into a microorganism.
It ships a tiny quantity of engineered microorganism to its clients which grow the colour via fermentation on renewable feedstocks such as sugar, yeast and plant-byproducts. The microorganisms divide every 20 minutes, resulting in dye liquor. This is then placed into standard dye machines, requiring no additional specialist equipment or chemicals.
It says that in convention dyeing, heavy metals and salts are introduced at the fixing stage to create a permanent bond between colour and fibre but the engineered microorganisms are able to concentrate the nutrient salts and metals that are already present in water to levels to facilitate this dye-fabric interaction.










